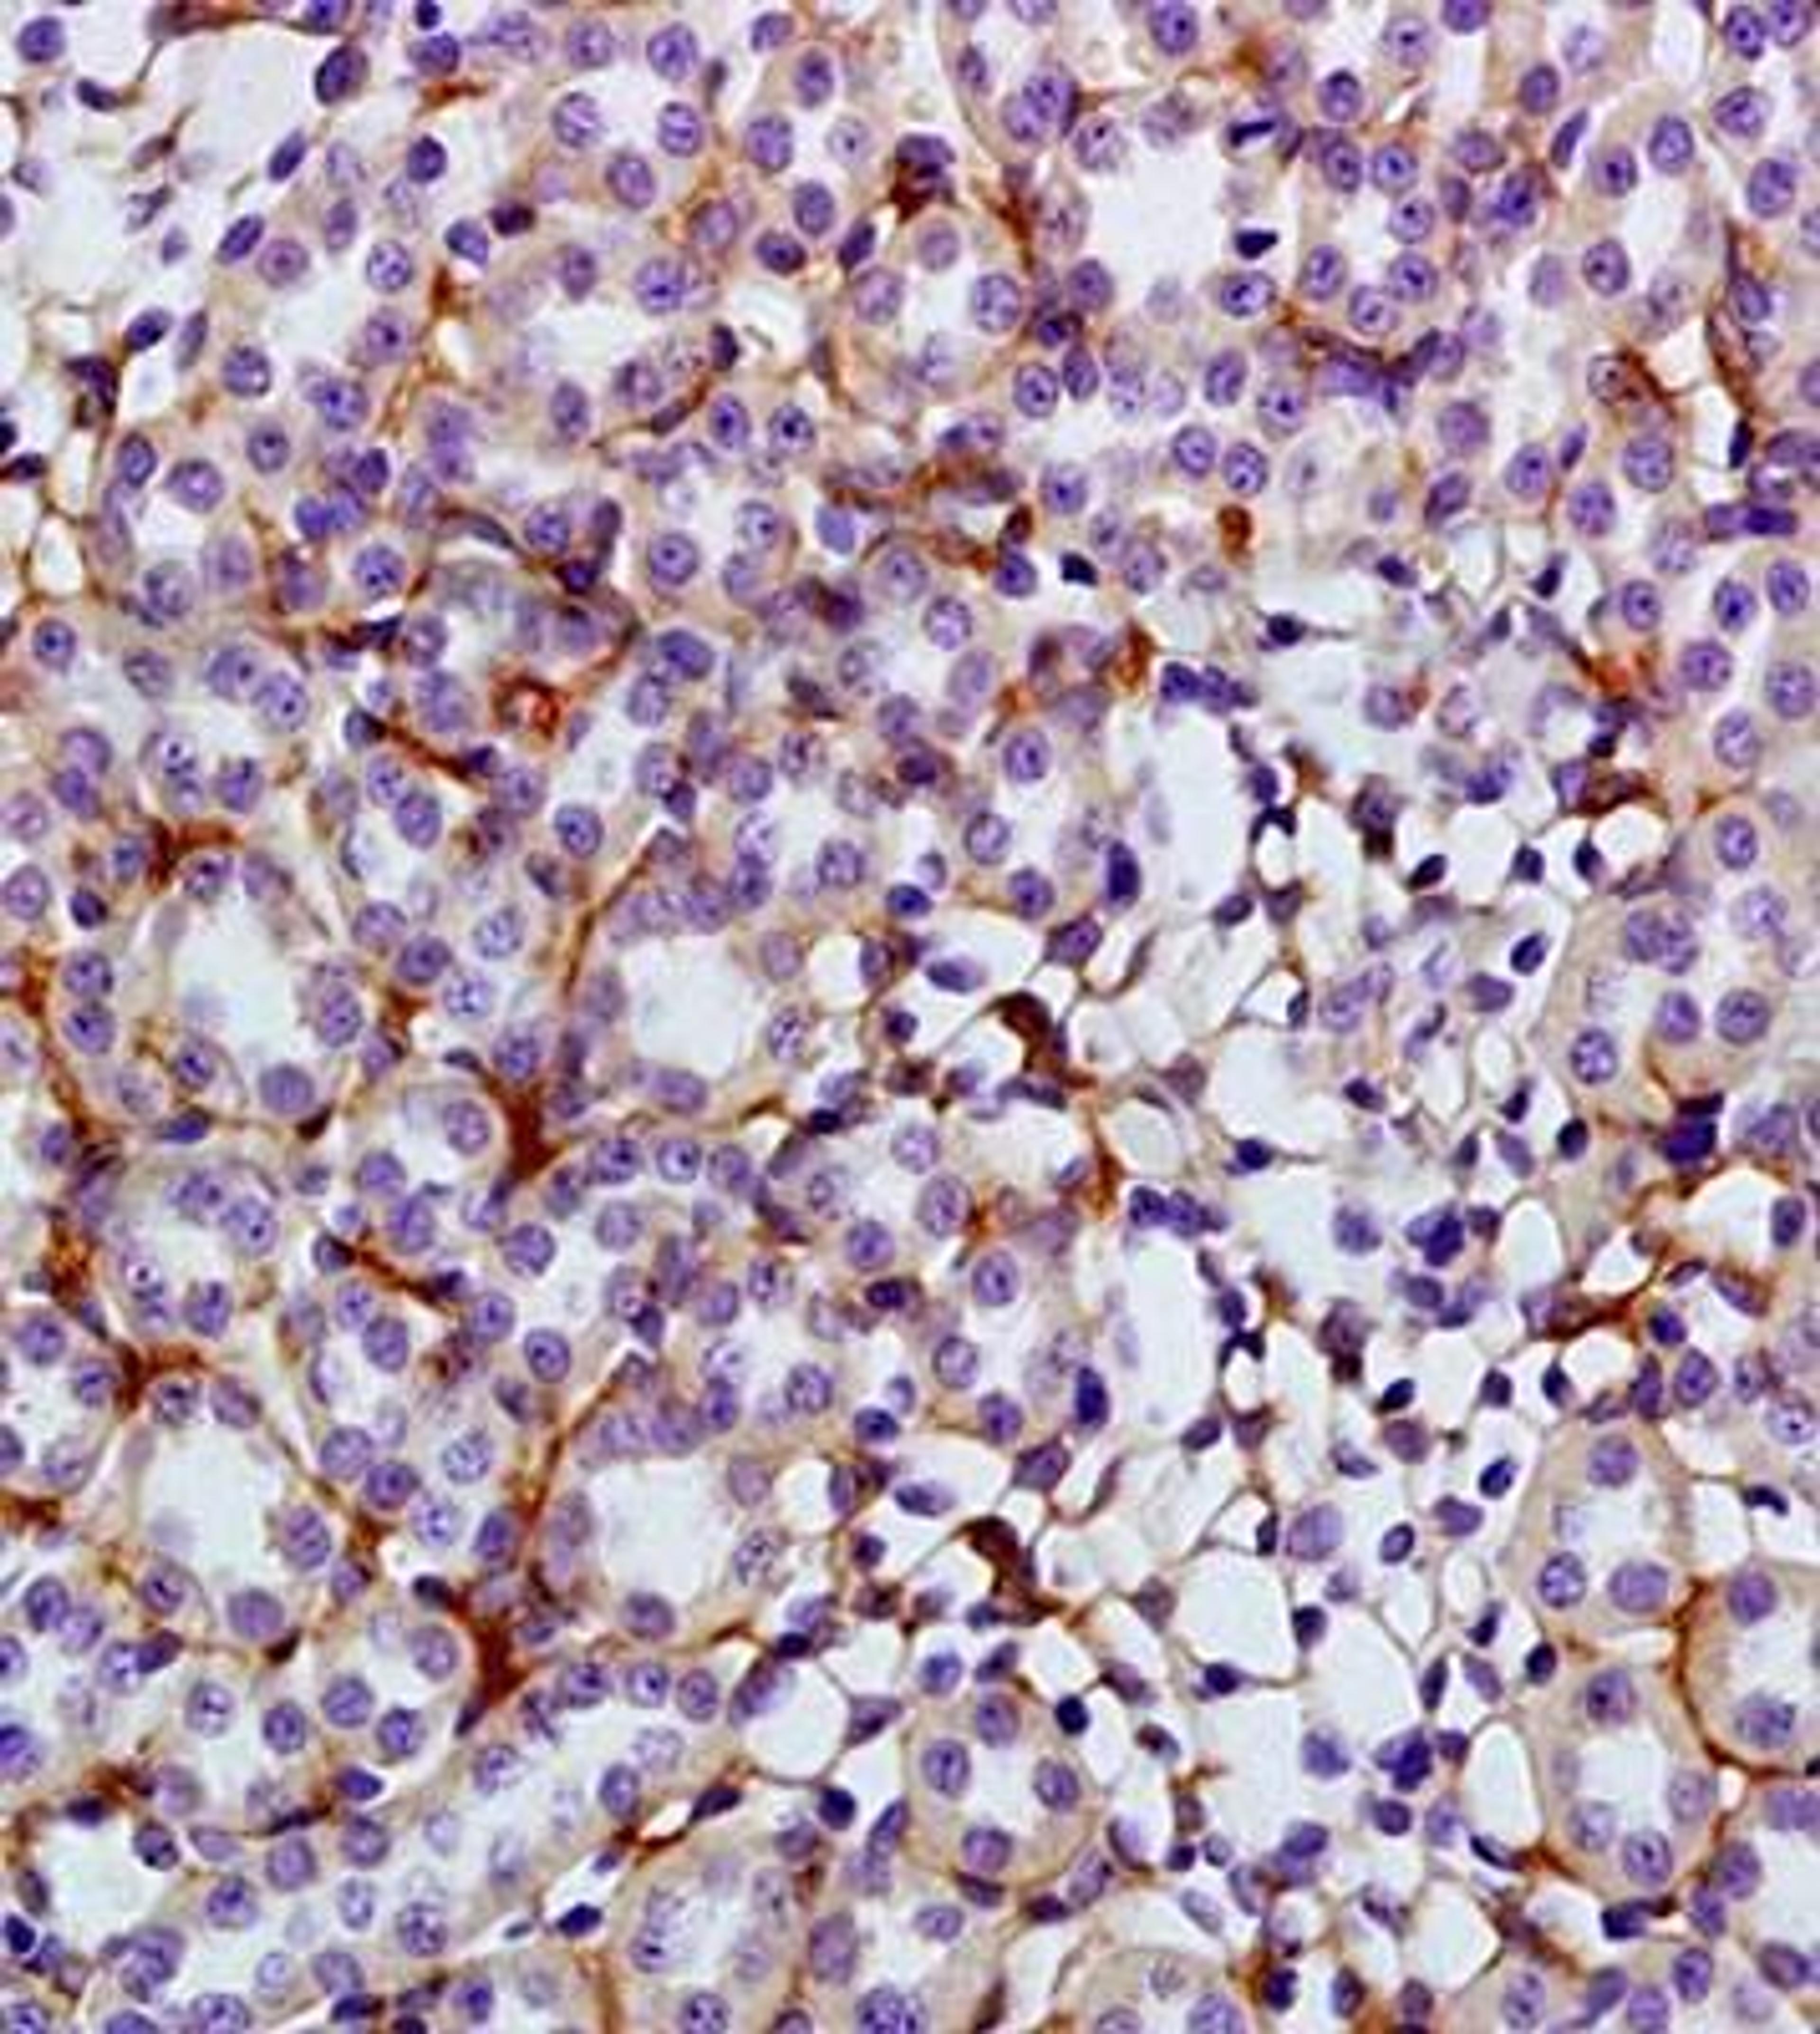
Immunohistochemical analysis of formalin fixed and paraffin embedded rat kidney tissue using GLUT4 antibody

GRP78 antibody
- Manufacturer
- Biorbyt
- Catalog Number
- orb107273
- Host
- Rabbit
- Reactivity
- Human, Mammalian, Mouse
- Applications
- Flow Cytometry, Immunofluorescence (Paraffin-Embedded Sections), Immunohistochemistry (Paraffin-Embedded Sections), Western Blotting